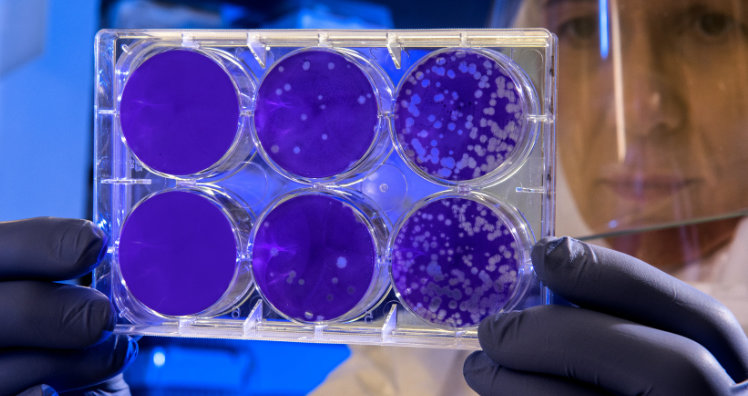

Forscher:innen des Agrarwissenschaftlichen Instituts der Texas A&M University haben ein Verfahren zur Herstellung von biologisch abbaubaren Kunststoffen entwickelt. Auf diese Weise könnten sie sowohl das Klima entlasten als auch dem Problem des Plastikmülls und des Mikroplastik entgegensteuern. Außerdem soll bei dem neuen Verfahren auf die Verwendung von fossilen Rohstoffen verzichtet werden.
Ethanol und Kohlenstoff als "Futter"
Die Professorin für Pflanzenpathologie und Mikrobiologie, Susie Dai, erklärt die neue Methode folgendermaßen: "Wir haben eine Art Zug mit zwei Waggons entwickelt. Im ersten Waggon setzen wir elektrische Energie ein, um CO2 in Ethanol und Kohlenstoffmoleküle umzuwandeln - ein Prozess, der als Elektrokatalyse bezeichnet wird. Im zweiten Waggon verstoffwechseln spezielle Bakterien Ethanol und Kohlenstoff und scheiden Biokunststoffe aus, die leicht abbaubar sind".
Bei Biokunststoffen handelt es sich zurzeit noch um ein teureres Material als erdölbasierte Polymere, doch Dai zeigt sich vorsichtig optimistisch. "Wenn es uns gelingt, mit dieser biologischen Technik Biokunststoffe in wirtschaftlicher Größenordnung herzustellen, könnte die Industrie auf die Herstellung von fossil basierten Kunststoffen verzichten und Alternativen herstellen, die weniger negative Umweltauswirkungen haben. Darüber hinaus ist die Minderung von CO2-Emissionen ebenfalls von Vorteil", ergänzt die Professorin weiters.
Bakterien möglicherweise auch Sprit-Lieferanten
Das entwickelte Verfahren könnte laut den verantwortlichen Wissenschaftler:innen aber nicht nur für die Herstellung von Polymeren geeignet sein. Weiters würde sich Dai vorstellen, speziell "trainierte" Bakterien einzusetzen, die CO2 in Kraftstoffe oder Rohstoffe für die chemische Industrie produzieren und auch hier Erdöl und Erdgas ersetzen.
www.tamu.edu

>
>




Kommentar veröffentlichen